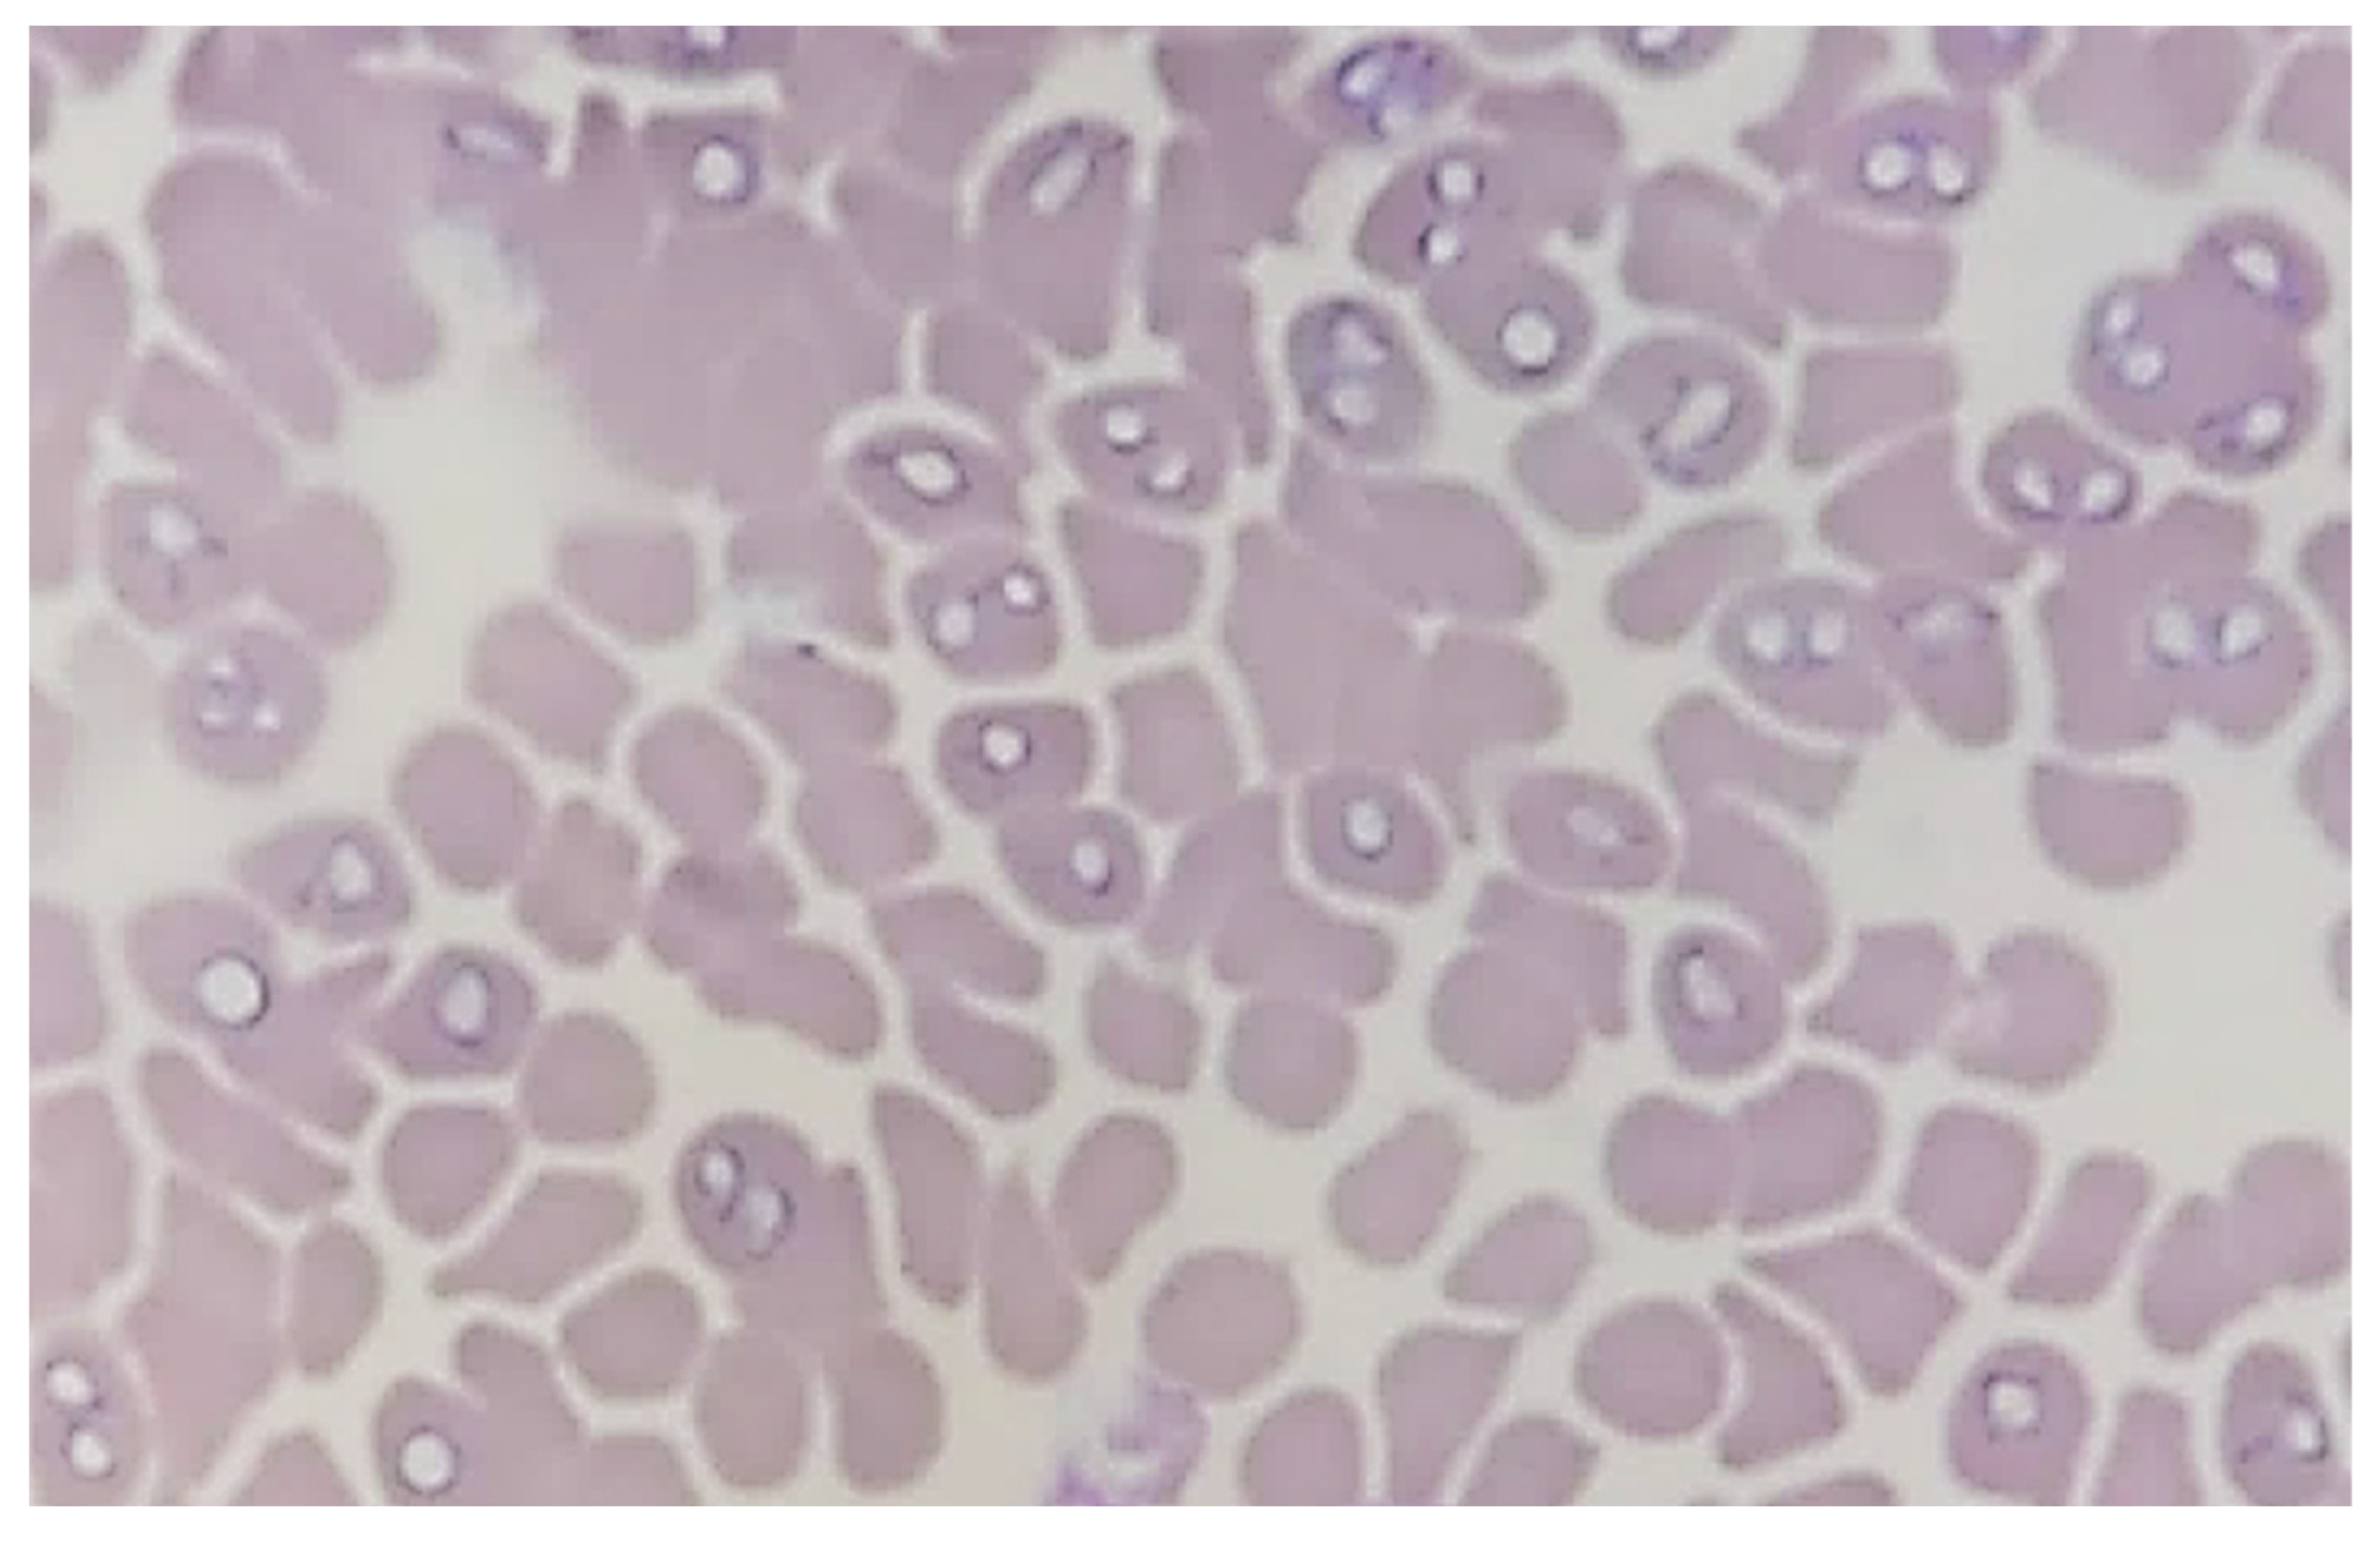
Pathogens 13 01104 g001

Abstract
Babesia canis is the parasite responsible for a life-threatening disease for dogs in Central Europe, of which the main vector is the ornate dog tick—Dermacentor reticulatus. The objective of the presented study was to assess the prevalence of Babesia infection in dogs with clinical suspicion of babesiosis, which tested positive for B. canis from locations where there is no or very limited information about dog exposure to this pathogen. In order to confirm the presence of this protozoan, blood samples were collected from dogs treated in veterinary clinics with suspicion of canine babesiosis. The samples were sent for microscopic analysis to Vetlab, a commercial veterinary diagnostic laboratory, to confirm the diagnosis. Overall, 3032 dog blood samples from Southern Poland were examined between 1 August 2018 and 31 December 2022 at the Vetlab laboratory. A total of 282 (9.3%) samples were found to be Babesia-positive using Wright–Giemsa stain peripheral blood smears, with an increase in two periods per year—April and October. Among the five voivodships, from which the laboratory analyzed blood samples, the highest number of Babesia-positive samples came from Częstochowa (Silesia) and its surroundings. Moreover, Babesia protozoans occurred more frequently in blood smears of pure-breed rather than mixed-breed dogs. The obtained results showed that infections with large Babesia in dogs from Southern Poland (with a special indication for the Śląskie Voivodship) should be taken into consideration during the differential diagnosis of tick-borne diseases at veterinary clinics. The presented study increases the vigilance and awareness of veterinarians and dog owners in this region, where babesiosis was very rarely diagnosed until date.
1. Introduction
Canine babesiosis is a major tick-borne disease in dogs, with a worldwide distribution [1,2,3]. The infection is caused by intraerythrocytic parasites of the Babesia genus (Piroplasmida: Babesidae), which are divided into large- or small-sized species, depending on their morphology and shape. There are two groups of Babesia species, based on size, that are pathogenic in dogs: small-sized, 1.5–2.5 µm (Babesia gibsoni, B. vulpes and B. conradae), and large-sized, 3.0–5.0 µm (B. canis, B. vogeli, B. rossi and Babesia spp. (Coco)) [4,5,6,7]. So far, only three of them, including B. canis, B. gibsoni and B. vulpes, have been reported in dogs from Poland. Babesia canis has been the most prevalent Babesia species reported in Poland, especially in central and eastern parts of this country, whereas cases of B. gibsoni and B. vulpes are extremely rare [3,6,7,8,9,10,11,12,13,14].
The main vector of B. canis is the ornate dog tick (Dermacentor reticulatus), which commonly occurs in eastern, western and central regions of Poland. Its geographical range is very closely related to the occurrence of canine babesiosis cases, with significant presence in eastern and central parts of the country [15,16,17,18]. Global warming and, as a result, climate and land change, have impacted the spread of new vectors, including the ornate dog tick, which is the second most common tick species (after Ixodes ricinus) in Central Europe. Moreover, tourism and travelling with dogs constantly increases the range of this tick species, at the same time introducing canine vector-borne diseases to new areas [19,20,21,22,23,24].
Canine babesiosis is a disease that may cause a variety of clinical signs, often unspecific, which include mild manifestations like apathy, weakness, dehydration and elevated temperature, as well as more severe symptoms, such as vomiting, diarrhea, icterus, splenomegaly, hemoglobinuria, renal failure or tachycardia [13,25,26]. The blood diagnostic test for canine babesiosis is based on the microscopic detection of pyriform parasites (trophozoites or merozoites) within infected erythrocytes using May–Grünwald Giemsa, Wright–Giemsa or Diff-Quick stained peripheral blood smears [25,26]. The method, according to diagnostic guidelines is the primary, low-cost direct test for canine babesiosis identification [27]. The detection of B. canis parasites in a blood smear is sometimes incidental, occurring during the routine verification of reduced platelet counts, which is performed in veterinary diagnostic laboratories. The observation of this protozoan in a blood smear is possible especially during acute symptomatic infection, whereas the chronic form is characterized by low and temporary parasitemia [28,29]. Babesia protozoans are most often detectable in peripheral blood between the 8 and the 21 day of infection after a tick bite. The presence of activated monocytes with a visible foamy cytoplasm or azurophilic granules in the cytoplasm of lymphocytes is a distinguished element in a microscopic examination of blood that may suggest Babesia infection in addition to common features like hemolytic anemia, leukopenia, neutropenia and thrombocytopenia. In commercial veterinary laboratories, the microscopic analysis of blood smears is the most frequently chosen diagnostic method for the identification of the vast majority of canine babesiosis cases. For low or transient parasitemia, molecular methods, such as the polymerase chain reaction (PCR), are recommended [25,26,30,31,32].
There is very limited information about the occurrence of canine babesiosis in Southern Poland, especially in Śląskie, Opolskie, Świętokrzyskie and Małopolskie voivodships [8,13]. The objective of the presented study is to assess the prevalence of Babesia infection in dogs with clinical suspicion of babesiosis, which tested positive for B. canis from locations, where there is no or very limited information about dog exposure to this pathogen and where only a few reports of this disease have been reported [8,13,20,21,33,34].
2. Materials and Methods
2.1. Data Collection and Analysis of Blood Samples
In this retrospective study, the prevalence of Babesia in dogs was assessed using data generated by the Vetlab veterinary laboratory (Katowice, Poland) on blood smears from 3032 dogs analyzed between 1 August 2018 and 31 December 2022. Blood samples were sent for microscopic analysis from veterinary clinics of Southern Poland, including Śląskie, Małopolskie, Podkarpackie, Świętokrzyskie and Lubelskie voivodships. All samples were collected by the clinicians during routine veterinary activity, when canine babesiosis was suspected. The laboratory received blood samples taken from the cephalic, saphenous or jugular veins by veterinary clinic staff were stored at room temperature (between 15 °C and 25 °C degrees) with ethylenediaminetetraacetic acid (EDTA) for microscopic analysis. Thin blood smears were prepared from the EDTA-treated blood samples and the Wright–Giemsa staining method with methanol, thiazine and eosin dyes (ELITechGroup SAS, Puteaux, France). They allowed for the microscopic evaluation (ZEISS Axiolab 5, Shanghai, China) of Babesia protozoans’ size and shape in order to classify them as large or small forms. Blood smears were performed on the same day as the blood collection.
No samples were taken for the purpose of this study. To ensure that data privacy results were collected without owner information or canine patient identification, only data about geographic provenance, season of diagnosis and breed were known for all the dogs. No information about clinical status, signs or other laboratory findings was available.
2.2. Data Analysis
Only Babesia-positive cases confirmed by the microscopic observation of protozoans in blood smears were included in the present study. The obtained data were documented in Microsoft Excel 2019 (Microsoft 365, Redmond, WA, USA). Statistical analysis was performed in Statistica Tibco (Software Inc., London, UK) version 13.3. A Chi-square test (χ2) with Yates’s correction was used to compare the categorical variables, and the results are given as percentages. Statistical significance was set at p < 0.05.
3. Results
3.1. Blood Smears
The microscopic evaluation of blood smears prepared from EDTA-treated blood samples showed the presence of pear-shaped trophozoites pointed at one end and rounded the other in large-sized (3.0–5.0 µm long) Babesia species, most likely Babesia canis (Figure 1). Three of the Babesia-positive blood smears were doubtful in microscopic observation, but no molecular analyses of these samples were ordered by veterinarians. Thereby, these samples were excluded from the pool of Babesia-positive samples.
Figure 1.
Babesia spp. trophozoites inside erythrocytes in blood smear stained by Wright–Giemsa method (100× magnification; ZEISS Axiolab 5, Shanghai, China).
3.2. Overall Data—Babesia-Positive Blood Samples
From 3032 blood samples examined between 1 August 2018 and 31 December 2022 at the Vetlab laboratory, 282 (9.3%) blood smears were positive for large-sized Babesia spp. (Table 1). The highest number of positive cases was noted in 2022 (n = 125), which corresponded with the highest canine babesiosis rate—11.29% (125 positive cases per 1107 examined samples).
Table 1.
Number and percent of large-sized Babesia spp.-positive blood samples examined between 2018 and 2022 in veterinary laboratory (Vetlab, Katowice).
3.3. Seasonal Dynamics of Canine Babesiosis
The number of babesiosis cases recorded in each month between 2018 and 2022 in the Vetlab laboratory is presented in Figure 2. The number of Babesia-positive cases increased bimodally, with a first peak in April, followed by a second peak in October, with a reduction in cases between June and August. Between 1 January and 31 December 2019, 2020, 2021 and 2022, a similar pattern of canine babesiosis cases was recorded, clearly reflecting the seasonal activity of D. reticulatus ticks. Additionally, a lower number of Babesia reports in 2019 and 2020 can be attributed to the COVID-19 pandemic, when mobility restrictions were in place.
Figure 2.
Monthly distribution of Babesia spp.-positive reports in Vetlab laboratory from 2018 to 2022. Explanations: no data on prevalence are available previous to August 2018.
3.4. Regional Distribution of Positive Babesia spp. Cases
Canine babesiosis cases were diagnosed in dog blood samples from five voivodships of Southern Poland, including Śląskie, Podkarpackie, Małopolskie, Świętokrzyskie and Lubelskie. Most often, babesiosis was diagnosed in Silesia (Śląskie Voivodship) n = 183, which constituted 64.9% of the total number of Babesia-positive cases, then in Subcarpathia (Podkarpackie Voivodship) n = 61 (21.63%) and Lesser Poland (Małopolskie Voivodship) n = 32 (11.35%), respectively (Figure 3).
Figure 3.
Percent [%] of Babesia spp. cases in particular voivodships of Southern Poland (2018–2022) with veterinary clinic locations with the highest prevalence of Babesia in dog blood samples [My Maps, Google Maps].
The highest number of Babesia cases came from Częstochowa (n = 37), Aleksandria (n = 30), Blachownia (n = 16) and Katowice (n = 14) in Silesia. In Subcarpathia, most positive cases came from Rzeszów (n = 22), Sędziszów Małopolski (n = 22) and Łańcut (n = 13) (Figure 3). The entire list of veterinary clinic locations, where canine babesiosis was confirmed, can be found in Supplementary Table S1.
Figure 4 shows the percent of positive Babesia reports in particular voivodships of Southern Poland per year from 2019 to 2022. The year 2018 was excluded from the annual analysis because the activity of the Vetlab laboratory began in August 2018.
Figure 4.
Percent [%] of Babesia spp.-positive reports in particular voivodships of Southern Poland in 2019, 2020, 2021 and 2022 in the Vetlab laboratory.
3.5. Statistical Analysis
Statistical analysis showed no significant difference between the percent of dogs examined as being positive for Babesia from 2018 to 2022, respectively: 2018 vs. 2019 (χ2 = 0.09; p = 0.77), 2018 vs. 2021 (χ2 = 0.26; p = 0.61), 2018 vs. 2022 (χ2 = 0.55; p = 0.46), 2019 vs. 2020 (χ2 = 0.09; p = 0.77), 2019 vs. 2021 (χ2 = 1.15; p = 0.28), 2019 vs. 2022 (χ2 = 1.70; p = 0.19), 2020 vs. 2021 (χ2 = 0.26; p = 0.61), and 2020 vs. 2022 (χ2 = 0.55; p = 0.46) (Table 1).
In contrast, a significant difference was observed between the number of Babesia-positive cases in Silesia and Subcarpathia (χ2 = 35.89; p ≤ 0.00001). In addition, dog blood samples were more often Babesia-positive in Silesia than in Lesser Poland (χ2 = 59.61; p ≤ 0.00001). Moreover, Babesia-positive cases were more frequently diagnosed in Subcarpathia than in Lesser Poland, but the difference was statistically insignificant (χ2 = 3.63; p = 0.057) (Figure 3).
3.6. Dog Breeds and Occurrence of Babesia spp.
Table 2 shows the number of Babesia-positive cases, including reports noted among pure- and mixed-breed dogs. Canine babesiosis was more often observed in pure-breed (n = 174; 61.7%), than mixed-breed dogs (n = 104; 36.9%). Among pure-breed dogs, German Shepherds were most frequently infected by Babesia protozoans (n = 23; 13.2% of pure-breed dogs). Only 1.4% Babesia positive dogs were classified as unknown breed (no information in the order from the veterinary clinic).
Table 2.
Dog breeds infected by Babesia spp. between August 2018 and December 2022.
4. Discussion
During the last decade, the number of canine babesiosis cases in Central Europe has been increasing. This may be a consequence of frequent travelling with companion animals and also expanding geographic ranges of ticks, which are vectors of Babesia protozoans [6,7,12,35,36,37]. In Poland, canine babesiosis is an endemic disease mostly diagnosed in regions located to the east of the Vistula River (Lubelskie, Mazowieckie and Podlaskie voivodships) [3,6,8,37]. There are only a few reports which describe the presence of canine babesiosis in dogs from western regions of Poland [22,38], and there is none or very limited knowledge about Babesia cases from Śląskie, Małopolskie, Podkarpackie and Świętokrzyskie voivodships [8,13,20,34,39].
The prevalence of canine babesiosis is strictly dependent on Dermacentor reticulatus presence, a main vector of Babesia canis in the natural habitat [40,41]. In Poland, the ornate dog tick has been detected in Dolnośląskie, Lubuskie, Wielkopolskie, Zachodniopomorskie, Kujawsko-Pomorskie, Pomorskie, Warmińsko-Mazurskie, Łódzkie, Podlaskie, Podkarpackie and Świętokrzyskie voivodships. Moreover, Masovia and Lublin’s surroundings are considered D. reticulatus endemic regions [3,20,21,33,36,42,43,44,45,46,47,48,49,50,51].
To our knowledge, this is the first retrospective study of canine babesiosis reports among dogs from regions of Southern Poland which includes data about geographic provenance, season of diagnosis and dog breed. A total of 3032 dog blood samples were examined in a Vetlab commercial veterinary diagnostic laboratory, and 282 of them were Babesia-positive. In this study, the data were collected from five voivodships of Poland: Śląskie, Podkarpackie, Małopolskie, Świętokrzyskie and Lubelskie. The majority of examined samples came from the Śląskie Voivodship, which was probably influenced by the Vetlab laboratory location (Katowice, Silesia). Out of 282 Babesia-positive samples, as many as 183 (64%) came from Silesia. The results provide very valuable information for veterinary personnel and dog owners from this region and should increase vigilance against this pathogenic agent. Until recently, apart from cases transmitted from other voivodships, B. canis did not pose a significant threat and was very rare in this area [13,34,39,52]. It should be mentioned that in the presented study, cases transferred from B. canis endemic regions cannot be excluded. On the other hand, even in case of partial introduction of Babesia cases from other voivodships, most probably, the vast majority of positive samples are autochthonous. There are unpublished data from veterinary clinicians that such cases have occurred for the last few years, but this topic requires further exploration.
A similar situation concerns the Świętokrzyskie Voivodship, a region that has not been examined at all for canine babesiosis, and which is not free from this pathogen (1.8% out of all positive samples, n = 5). In turn, the presence of Babesia-positive samples in Subcarpathia (n = 61 positive samples), Lesser Poland (n = 32) and Lubelskie Voivodship (n = 1) was expected, because the occurrence of canine babesiosis was already confirmed there [8,9,22]. Furthermore, there are many articles suggesting higher prevalences of B. canis in D. reticulatus ticks collected from vegetation and companion animals in Central and Eastern Europe compared to the western part of the continent [3,8,20,21,37,38,53,54,55,56,57,58,59,60,61]. This difference may be a result of the Central European gap, which separates central-eastern and western D. reticulatus populations. In Poland, the D. reticulatus-free zone spreads across Western Pomerania and Pomerania in the north to Opolskie Voivodship, Silesia, Lesser Poland, and part of Subcarpathia in the south [20]. However, recent papers confirmed presence of D. reticulatus on companion animals in Silesia [13,39,52] and described a new endemic location of the ornate dog tick in this voivodship [62]. The presented results support earlier predictions on the disappearing of the D. reticulatus spatial gap in Central Europe in the near future [17,63]. The process will probably continue because of humans travelling with pets and livestock, as well as the presence of wildlife migration routes in this area [64].
The presented analysis of the data from the veterinary diagnostic laboratory showed places with the highest prevalence of Babesia cases in particular voivodships of Southern Poland. A significant number of cases came from three locations in the Śląskie Voivodship, like Częstochowa (city), Aleksandria (village, Konopiska district) and Blachownia (city), which are located between the forested areas, approximately 20 km apart, in the basin of the Warta and Stradomka Rivers. The accumulation of Babesia cases in dogs from those locations may suggest the presence of a next endemic foci(s) for D. reticulatus in Silesia; therefore, this region should be taken into consideration for the future monitoring of the ornate dog tick population. The rapid increase in canine babesiosis in this area suggests changes in the circulation of this pathogen among reservoirs and vectors probably caused by climatic factors. It is highly probable that D. reticulatus ticks are transported on animals migrating to this region from endemic locations in Poland or eastern Germany [16,35,65,66].
In the presented study, the seasonality of clinical babesiosis cases was observed with peaks in April and October in accordance with the seasonal activity of D. reticulatus, which is consistent with the results of other authors [67,68]. Out of 282 Babesia-positive dogs, 174 (61.7%) were pure-breed and 104 (36.9 were mixed-breed. This may suggest that pure-breed dogs are more prone to infection caused by this protozoan species. Adaszek et al. [8] confirmed this observation in their study, where 106 dogs infected by B. canis were pure-breeds in comparison with 52 positive mixed-breed dogs. On the other hand, the study from Hungary [68] showed no significant difference in prevalence of canine babesiosis between pure- and mixed-breed dogs, which may suggest that babesiosis is not related to the predisposition of a particular breed, but with the living condition of the dog [69].
In this study, no records of travel history were available on Babesia-positive dogs in the laboratory database, so “travel infections” could not be excluded, which should be taken into consideration in future analysis. Due to the retrospective nature of this study, there was no possibility for the molecular confirmation of the species of large-sized Babesia, which were detected microscopically in analyzed blood smears. Nevertheless, it may be assumed that all detected Babesia-positive samples are B. canis, because they belonged to the large Babesia group, and so far, only this species has been confirmed in dogs living in Poland [12]. Despite the limitations, such as a lack of information about dogs’ clinical status and symptoms, lower-sensitivity of microscopic compared to molecular diagnosis, and no additional confirmation of positive samples by PCR-based diagnostic tools (no information in the order from veterinary clinics), this study provides many valuable insights for clinicians and researchers about the occurrence of canine babesiosis in Southern Poland.
In conclusion, from 3032 dog blood samples analyzed by Vetlab Sp. z o. o. between 1 August 2018 and 31 December 2022, a 9.3% prevalence (262/3032) for Babesia infection was detected. Primarily, the obtained results showed that infections with Babesia spp. in dogs from this region (with a special indication for the Śląskie Voivodship) should be taken into consideration during the differential diagnosis of tick-borne diseases at veterinary clinics. Moreover, the results suggest a shift in occurrence of this pathogenic species to these regions of Poland, where, so far, canine babesiosis was noted sporadically, mainly among visiting dogs. Further observations in the upcoming years are necessary in this region in order to confirm the new endemic location for this parasite.
Supplementary Materials
The following supporting information can be downloaded at https://www.mdpi.com/article/10.3390/pathogens13121104/s1, Table S1: Number of positive Babesia spp. reports between 2018 and 2022 with locations of veterinary clinics, which sent the blood samples for analysis in the Vetlab laboratory.
Author Contributions
Conceptualization, O.P.; methodology, P.I. and O.P.; software, P.I. and O.P.; validation, P.I. and O.P.; formal analysis, O.P.; investigation, O.P., P.I. and B.W.; resources, O.P., P.I. and B.W.; data curation, O.P.; writing—original draft preparation, O.P., P.I. and B.W.; writing—review and editing, K.S., R.W. and M.K.; visualization, O.P.; supervision, O.P.; project administration, O.P.; funding acquisition, O.P. All authors have read and agreed to the published version of the manuscript.
Funding
This research was funded by the Medical University of Silesia in Katowice, with the following grant numbers: PCN-2-008/K/2/I, Ectoparasites collected from domestic dogs and cats as a source of pathogens for companion animals and a potential zoonotic threat to inhabitants of the Silesian and Opole voivodeships; BNW-2-022/K/4/I, Analysis of the occurrence of symptomatic cases of selected vector-borne diseases, including zoonoses, in domestic animals from Southern Poland and BNW-1-024/N/3/I, Assessment of the risk of exposure to allergenic and parasitic mites in case of forensic and epidemiological analyses.
Institutional Review Board Statement
Ethical review and approval were waived for this study due to this study being retrospective in nature and describing the results of diagnostic samples submitted for testing to a commercial diagnostic laboratory Vetlab Sp. z o. o. All experimental protocols were approved by the Vetlab Sp. z o. o., Veterinary Diagnostic Laboratory, Wodzisławska Str 6, 52-017, Wrocław, Poland. All methods were carried out in accordance with the relevant guidelines and regulations in the Vetlab Sp. z o. o., Veterinary Diagnostic Laboratory, Wodzisławska Str 6, 52-017, Wrocław, Poland. This study was carried out in compliance with the ARRIVE guidelines. The authors declare that no other approval was needed.
Informed Consent Statement
Not applicable.
Data Availability Statement
Data are contained within the article and Supplementary Materials.
Conflicts of Interest
The authors declare no conflicts of interest.
References
- De Marco, M.d.M.F.; Hernández-Triana, L.M.; Phipps, L.P.; Hansford, K.; Mitchell, E.S.; Cull, B.; Swainsbury, C.S.; Fooks, A.R.; Medlock, J.M.; Johnson, N. Emergence of Babesia canis in southern England. Parasites Vectors 2017, 10, 241. [Google Scholar] [CrossRef] [PubMed]
- Halos, L.; Lebert, I.; Abrial, D.; Danlois, F.; Garzik, K.; Rodes, D.; Schillmeier, M.; Ducrot, C.; Guillot, J. Questionnaire-based survey on the distribution and incidence of canine babesiosis in countries of Western Europe. Parasite 2014, 21, 13. [Google Scholar] [CrossRef]
- Welc-Falęciak, R.; Rodo, A.; Siński, E.; Bajer, A. Babesia canis and other tick-borne infections in dogs in Central Poland. Vet. Parasitol. 2009, 166, 191–198. [Google Scholar] [CrossRef] [PubMed]
- Radzijevskaja, J.; Mardosaitė-Busaitienė, D.; Aleksandravičienė, A.; Karvelienė, B.; Razgūnaitė, M.; Stadalienė, I.; Paulauskas, A. Genetic Diversity of Babesia canis Strains in Dogs in Lithuania. Microorganisms 2022, 10, 1446. [Google Scholar] [CrossRef]
- Baneth, G.; Florin-Christensen, M.; Cardoso, L.; Schnittger, L. Reclassification of Theileria annae as Babesia vulpes sp. nov. Parasites Vectors 2015, 8, 207. [Google Scholar] [CrossRef]
- Solano-Gallego, L.; Sainz, Á.; Roura, X.; Estrada-Peña, A.; Miró, G. A review of canine babesiosis: The European perspective. Parasites Vectors 2016, 9, 336. [Google Scholar] [CrossRef]
- Baneth, G. Babesia of domestic dogs. In Parasitic Protozoa of Farm Animals and Pets; Florin-Christensen, M., Schnittger, L., Eds.; Springer: New York, NY, USA, 2018; pp. 241–258. [Google Scholar]
- Adaszek, Ł.; Carbonero Martinez, A.; Winiarczyk, S. The factors affecting the distribution of babesiosis in dogs in Poland. Vet. Parasitol. 2011, 181, 160–165. [Google Scholar] [CrossRef]
- Łyp, P.; Bartnicki, M.; Staniec, M.; Winiarczyk, S.; Adaszek, Ł. Occurrence of different strains of Babesia canis in dogs in eastern Poland. J. Vet. Res. 2016, 60, 423–427. [Google Scholar] [CrossRef][Green Version]
- Tołkacz, K.; Kretschmer, M.; Nowak, S.; Mysłajek, R.W.; Alsarraf, M.; Wężyk, D.; Bajer, A. The first report on Hepatozoon canis in dogs and wolves in Poland: Clinical and epidemiological features. Parasites Vectors 2023, 16, 313. [Google Scholar] [CrossRef] [PubMed]
- Teodorowski, O.; Kalinowski, M.; Skrzypczak, M.; Witt, K.; Madany, J.; Winiarczyk, S.; Adaszek, Ł. Babesia gibsoni infection in dogs in Poland. Pol. J. Vet. Sci. 2020, 23, 469–471. [Google Scholar] [CrossRef]
- Bajer, A.; Beck, A.; Beck, R.; Behnke, J.M.; Dwużnik-Szarek, D.; Eichenberger, R.M.; Farkas, R.; Fuehrer, H.P.; Heddergott, M.; Jokelainen, P.; et al. Babesiosis in Southeastern, Central and Northeastern Europe: An emerging and re-emerging Tick-Borne Disease of humans and animals. Microorganisms 2022, 10, 945. [Google Scholar] [CrossRef]
- Pawełczyk, O.; Kotela, D.; Asman, M.; Witecka, J.; Wilhelmsson, P.; Bubel, P.; Solarz, K. The First Records of Canine Babesiosis in Dogs from Dermacentor reticulatus—Free Zone in Poland. Pathogens 2022, 11, 1329. [Google Scholar] [CrossRef]
- Adaszek, L.; Winiarczyk, S. Molecular characterization of Babesia canis canis isolates from naturally infected dogs in Poland. Vet. Parasitol. 2008, 152, 235–241. [Google Scholar] [CrossRef] [PubMed]
- Zając, Z.; Woźniak, A.; Kulisz, J. Density of Dermacentor reticulatus Ticks in Eastern Poland. Int. J. Environ. Res. Public Health 2020, 17, 2814. [Google Scholar] [CrossRef] [PubMed]
- Karbowiak, G. The occurrence of the Dermacentor reticulatus tick—Its expansion to new areas and possible causes. Ann. Parasitol. 2014, 60, 37–47. [Google Scholar]
- Földvári, G.; Široký, P.; Szekeres, S.; Majoros, G.; Sprong, H. Dermacentor reticulatus: A vector on the rise. Parasites Vectors 2016, 9, 314. [Google Scholar] [CrossRef]
- Chitimia-Dobler, L. Spatial distribution of Dermacentor reticulatus in Romania. Vet. Parasitol. 2015, 214, 219–223. [Google Scholar] [CrossRef]
- Bullová, E.; Lukán, M.; Stanko, M.; Petko, B. Spatial distribution of Dermacentor reticulatus tick in Slovakia in the beginning of the 21st century. Vet. Parasitol. 2009, 165, 357–360. [Google Scholar] [CrossRef] [PubMed]
- Dwużnik-Szarek, D.; Mierzejewska, E.J.; Rodo, A.; Goździk, K.; Behnke-Borowczyk, J.; Kiewra, D.; Kartawik, N.; Bajer, A. Monitoring the expansion of Dermacentor reticulatus and occurrence of canine babesiosis in Poland in 2016–2018. Parasites Vectors 2021, 14, 267. [Google Scholar] [CrossRef]
- Dwużnik-Szarek, D.; Mierzejewska, E.J.; Kiewra, D.; Czułowska, A.; Robak, A.; Bajer, A. Update on prevalence of Babesia canis and Rickettsia spp. in adult and juvenile Dermacentor reticulatus ticks in the area of Poland (2016–2018). Sci. Rep. 2022, 12, 5755. [Google Scholar] [CrossRef] [PubMed]
- Miró, G.; Wright, I.; Michael, H.; Burton, W.; Hegarty, E.; Rodón, J.; Buch, J.; Pantchev, N.; von Samson-Himmelstjerna, G. Seropositivity of main vector-borne pathogens in dogs across Europe. Parasites Vectors 2022, 15, 189. [Google Scholar] [CrossRef] [PubMed]
- Słodki, J.; Jasik, K.P.; Kępa, M.; Idzik, D.; Wojtyczka, R.D. Tick-transmitted diseases caused by apicomplexa. Acta Protozool. 2011, 50, 155–161. [Google Scholar]
- Zając, V.; Wójcik-Fatla, A.; Sawczyn, A.; Cisak, E.; Sroka, J.; Kloc, A.; Zając, Z.; Buczek, A.; Dutkiewicz, J.; Bartosik, K. Prevalence of infections and co-infections with 6 pathogens in Dermacentor reticulatus ticks collected in eastern Poland. Ann. Agric. Environ. Med. 2017, 24, 26–32. [Google Scholar] [CrossRef]
- Petra, B.; Josipa, K.; Renata, B.R.; Vladimir, M. Canine babesiosis: Where do we stand? Acta Vet. 2018, 68, 127–160. [Google Scholar] [CrossRef]
- Kostro, K.; Stojecki, K.; Grzybek, M.; Tomczuk, K. Characteristics, immunological events, and diagnostics of Babesia spp. infection, with emphasis on Babesia canis. Bull. Vet. Inst. Pulawy 2015, 59, 495–504. [Google Scholar] [CrossRef]
- Kuleš, J.; Potocnakova, L.; Bhide, K.; Tomassone, L.; Fuehrer, H.P.; Horvatić, A.; Galan, A.; Guillemin, N.; Nižić, P.; Mrljak, V. The Challenges and Advances in Diagnosis of Vector-Borne Diseases: Where Do We Stand? Vector-Borne Zoonotic Dis. 2017, 17, 285–296. [Google Scholar] [CrossRef] [PubMed]
- Adaszek, Ł.; Łyp, P.; Winiarczyk, S. Babeszjoza psów w świetle obserwacji własnych. [Canine babesiosis in the light of own observations]. Vet. Life 2017, 2, 9–11. [Google Scholar]
- Reddy, B.S.; Sivajothi, S.; Reddy, L.S.S.; Raju, K.G.S. Clinical and laboratory findings of Babesia infection in dogs. J. Parasit. Dis. 2016, 40, 268–272. [Google Scholar] [CrossRef]
- Shortt, H.E. Babesia canis: The life cycle and laboratory maintenance in its arthropod and mammalian hosts. Int. J. Parasitol. 1973, 3, 119–148. [Google Scholar] [CrossRef]
- Lempereur, L.; Beck, R.; Fonseca, I.; Marques, C.; Duarte, A.; Santos, M.; Zúquete, S.; Gomes, J.; Walder, G.; Domingos, A. Guidelines for the Detection of Babesia and Theileria Parasites. Vector-Borne Zoonotic Dis. 2017, 17, 51–65. [Google Scholar] [CrossRef]
- Schetters, T. Mechanisms Involved in the Persistence of Babesia canis Infection in Dogs. Pathogens 2019, 8, 94. [Google Scholar] [CrossRef]
- Mierzejewska, E.J.; Estrada-Peña, A.; Alsarraf, M.; Kowalec, M.; Bajer, A. Mapping of Dermacentor reticulatus expansion in Poland in 2012–2014. Ticks Tick-Borne Dis. 2016, 7, 94–106. [Google Scholar] [CrossRef] [PubMed]
- Cuber, P.; Solarz, K.; Mosiałek, A.; Jakubiec-Spanier, M.; Spanier, A. The first record and occurrence of the ornate cow tick Dermacentor reticulatus (Fabricius, 1794) in south-western Poland. Ann. Parasitol. 2013, 59, 49–51. [Google Scholar]
- Drehmann, M.; Springer, A.; Lindau, A.; Fachet, K.; Mai, S.; Thoma, D.; Schneider, C.R.; Chitimia-Dobler, L.; Bröker, M.; Dobler, G.; et al. The Spatial Distribution of Dermacentor Ticks (Ixodidae) in Germany—Evidence of a Continuing Spread of Dermacentor reticulatus. Front. Vet. Sci. 2020, 7, 578220. [Google Scholar] [CrossRef] [PubMed]
- Zygner, W.; Wędrychowicz, H. Occurrence of the hard ticks in dogs from the Warsaw area. Ann. Agric. Environ. Med. 2006, 13, 355–359. [Google Scholar] [PubMed]
- Zygner, W.; Górski, P.; Wedrychowicz, H. Detection of the DNA of Borrelia afzelii, Anaplasma phagocytophilum and Babesia canis in blood samples from dogs in Warsaw. Vet. Rec. 2009, 64, 465–467. [Google Scholar] [CrossRef] [PubMed]
- Krol, N.; Kiewra, D.; Lonc, E.; Janaczyk, B.; Chodorowska-Skubiszewska, A.; Dzięcioł, M.; Gola, M.; Gruszka, R.; Jackowska-Szlachcic, E.; Jagiełło, M.; et al. Dermacentor reticulatus (Fabricius, 1794) and Babesia canis (Piana et Galli-Valerio, 1895) as the Parasites of Companion Animals (Dogs and Cats) in the Wroclaw Area, South-Western Poland. Ann. Parasitol. 2016, 62, 125–130. [Google Scholar] [PubMed]
- Buczek, A.; Buczek, W.; Rudek, M.; Asman, M.; Świsłocka, M.; Bartosik, K. Occurrence of Dermacentor reticulatus in central-southern Poland, and potential threats to human and animal health. Ann. Agric. Environ. Med. 2024, 31, 29–36. [Google Scholar] [CrossRef]
- Sprong, H.; Fonville, M.; Docters van Leeuwen, A.; Devillers, E.; Ibañez-Justicia, A.; Stroo, A.; Hansford, K.; Cull, B.; Medlock, J.; Heyman, P.; et al. Detection of pathogens in Dermacentor reticulatus in northwestern Europe: Evaluation of a high-throughput array. Heliyon 2019, 5, e01270. [Google Scholar] [CrossRef]
- Buczek, A.; Bartosik, K.; Zając, Z. Changes in the activity of adult stages of Dermacentor reticulatus (Ixodida: Amblyommidae) induced by weather factors in eastern Poland. Parasites Vectors 2014, 7, 245. [Google Scholar] [CrossRef] [PubMed]
- Bartosik, K.; Wiśniowski, Ł.; Buczek, A. Abundance and seasonal activity of adult Dermacentor reticulatus (Acari: Amblyommidae) in eastern Poland in relation to meteorological conditions and the photoperiod. Ann. Agric. Environ. Med. 2011, 18, 340–344. [Google Scholar]
- Zając, Z.; Bartosik, K.; Buczek, A. Factors influencing the distribution and activity of Dermacentor reticulatus (F.) ticks in an anthropopressure-unaffected area in central-eastern Poland. Ann. Agric. Environ. Med. 2016, 23, 270–275. [Google Scholar] [CrossRef] [PubMed]
- Karbowiak, G. Changes in the occurrence range of hosts cause the expansion of the ornate dog tick Dermacentor reticulatus (Fabricius, 1794) in Poland. Biologia 2022, 77, 1513–1522. [Google Scholar] [CrossRef]
- Karbowiak, G.; Kiewra, D. New locations of Dermacentor reticulatus ticks in Western Poland: The first evidence of the merge in D. reticulatus occurrence areas? Wiadomości Parazytol. 2010, 56, 333–340. [Google Scholar]
- Kiewra, D.; Czułowska, A. Evidence for an increased distribution range of Dermacentor reticulatus in south-west Poland. Exp. Appl. Acarol. 2013, 59, 501–506. [Google Scholar] [CrossRef] [PubMed][Green Version]
- Kiewra, D.; Szymanowski, M.; Czułowska, A.; Kolanek, A. The local-scale expansion of Dermacentor reticulatus ticks in Lower Silesia, SW Poland. Ticks Tick-Borne Dis. 2021, 12, 101599. [Google Scholar] [CrossRef] [PubMed]
- Kubiak, K.; Sielawa, H.; Dziekońska-Rynko, J.; Kubiak, D.; Rydzewska, M.; Dzika, E. Dermacentor reticulatus ticks (Acari: Ixodidae) distribution in north-eastern Poland: An endemic area of tick-borne diseases. Exp. Appl. Acarol. 2018, 75, 289–298. [Google Scholar] [CrossRef] [PubMed]
- Kubiak, K.; Szymańska, H.; Dziekońska-Rynko, J.; Tylkowska, A.; Dmitryjuk, M.; Dzika, E. Tick-borne pathogens in questing adults Dermacentor reticulatus from the Eastern European population (north-eastern Poland). Sci. Rep. 2024, 14, 698. [Google Scholar] [CrossRef] [PubMed]
- Zając, Z.; Obregon, D.; Foucault-Simonin, A.; Wu-Chuang, A.; Moutailler, S.; Galon, C.; Kulisz, J.; Woźniak, A.; Bartosik, K.; Cabezas-Cruz, A. Disparate dynamics of pathogen prevalence in Ixodes ricinus and Dermacentor reticulatus ticks occurring sympatrically in diverse habitats. Sci. Rep. 2023, 13, 10645. [Google Scholar] [CrossRef]
- Zając, Z.; Kulisz, J.; Woźniak, A.; Obregón, D.; Foucault-Simonin, A.; Bartosik, K.; Moutailler, S.; Cabezas-Cruz, A. Spatial Distribution and Pathogen Profile of Dermacentor reticulatus Ticks in Southeastern Poland: A Genetic and Environmental Analysis. Transbound. Emerg. Dis. 2024, 2024, 5458278. [Google Scholar] [CrossRef]
- Kocoń, A.; Nowak-Chmura, M.; Asman, M. Assessment of the species composition of ticks attacking dogs and domestic cats in the Małopolska and Silesian provinces. Syst. Appl. Acarol. 2022, 7, 1509–1517. [Google Scholar] [CrossRef]
- Birkenheuer, A.J.; Buch, J.; Beall, M.J.; Braff, J.; Chandrashekar, R. Global distribution of canine Babesia species identified by a commercial diagnostic laboratory. Vet. Parasitol. Reg. Stud. Rep. 2020, 22, 100471. [Google Scholar] [CrossRef]
- Wójcik-Fatla, A.; Zając, V.; Sawczyn, A.; Cisak, E.; Dutkiewicz, J. Babesia spp. in questing ticks from eastern Poland: Prevalence and species diversity. Parasitol. Res. 2015, 114, 3111–3116. [Google Scholar] [CrossRef]
- Mierzejewska, E.J.; Pawełczyk, A.; Radkowski, M.; Welc-Falęciak, R.; Bajer, A. Pathogens vectored by the tick, Dermacentor reticulatus, in endemic regions and zones of expansion in Poland. Parasites Vectors 2015, 8, 490. [Google Scholar] [CrossRef]
- Grochowska, A.; Dunaj-Małyszko, J.; Pancewicz, S.; Czupryna, P.; Milewski, R.; Majewski, P.; Moniuszko-Malinowska, A. Prevalence of Tick-Borne Pathogens in Questing Ixodes ricinus and Dermacentor reticulatus Ticks Collected from Recreational Areas in Northeastern Poland with Analysis of Environmental Factors. Pathogens 2022, 11, 468. [Google Scholar] [CrossRef] [PubMed]
- Grochowska, A.; Dunaj, J.; Pancewicz, S.; Czupryna, P.; Majewski, P.; Wondim, M.; Tryniszewska, E.; Moniuszko-Malinowska, A. Detection of Borrelia burgdorferi s.l., Anaplasma phagocytophilum and Babesia spp. in Dermacentor reticulatus ticks found within the city of Białystok, Poland—First data. Exp. Appl. Acarol. 2021, 85, 63–73. [Google Scholar] [CrossRef]
- Dunaj, J.; Trzeszczkowski, A.; Moniuszko-Malinowska, A.; Rutkowski, K.; Pancewicz, S. Assessment of tick-borne pathogens presence in Dermacentor reticulatus ticks in north-eastern Poland. Adv. Med. Sci. 2021, 66, 113–118. [Google Scholar] [CrossRef] [PubMed]
- Bajer, A.; Kowalec, M.; Levytska, V.A.; Mierzejewska, E.J.; Alsarraf, M.; Poliukhovych, V.; Rodo, A.; Wężyk, D.; Dwużnik-Szarek, D. Tick-Borne Pathogens, Babesia spp. and Borrelia burgdorferi s.l., in Sled and Companion Dogs from Central and North-Eastern Europe. Pathogens 2022, 11, 499. [Google Scholar] [CrossRef]
- Mierzejewska, E.J.; Dwużnik, D.; Koczwarska, J.; Stańczak, Ł.; Opalińska, P.; Krokowska-Paluszak, M.; Wierzbicka, A.; Górecki, G.; Bajer, A. The red fox (Vulpes vulpes), a possible reservoir of Babesia vulpes, B. canis and Hepatozoon canis and its association with the tick Dermacentor reticulatus occurrence. Ticks Tick-Borne Dis. 2021, 12, 101551. [Google Scholar] [CrossRef] [PubMed]
- Zygner, W.; Gójska-Zygner, O.; Bartosik, J.; Górski, P.; Karabowicz, J.; Kotomski, G.; Norbury, L.J. Canine Babesiosis Caused by Large Babesia Species: Global Prevalence and Risk Factors-A Review. Animals 2023, 13, 2612. [Google Scholar] [CrossRef] [PubMed]
- Asman, M.; Bartosik, K.; Jakubas-Zawalska, J.; Świętek, A.; Witecka, J. A New Endemic Locality of Dermacentor reticulatus in Central–Southern Poland and Its Potential Epidemiological Implications. Insects 2024, 15, 580. [Google Scholar] [CrossRef] [PubMed]
- Kloch, A.; Mierzejewska, E.J.; Karbowiak, G.; Slivinska, K.; Alsarraf, M.; Rodo, A.; Kowalec, M.; Dwużnik, D.; Didyk, Y.M.; Bajer, A. Origins of recently emerged foci of the tick Dermacentor reticulatus in central Europe inferred from molecular markers. Vet. Parasitol. 2017, 237, 63–69. [Google Scholar] [CrossRef]
- Wymazał, A.; Nowak, S.; Mysłajek, R.W.; Bajer, A.; Welc-Falęciak, R.; Szewczyk, M.; Kwiatkowska, I.; Stępniak, K.M.; Figura, M.; Kloch, A. Tick-borne infections in wolves from an expanding population in Eastern Europe. Ticks Tick-Borne Dis. 2024, 15, 102272. [Google Scholar] [CrossRef] [PubMed]
- Pawełczyk, O.; Góra, S.; Kotela, D.; Solarz, K. Kleszcz pospolity i kleszcz łąkowy jako groźne gatunki wektorowe dla psów domowych. [The castor bean tick and the ornate dog tick as vector species dangerous for domestic dogs]. Weter. w Prakt. 2022, 7–8, 55–60. [Google Scholar]
- Adaszek, Ł.; Staniec, M.; Dokuzeylül, B.; Pisarek, M.; Skrzypczak, M.; Żółkiewski, P.; Rutkowska-Szulczyk, M.; Deneka, Ł.; Or, M.E.; Winiarczyk, S. Vector-borne diseases imported to Poland between 2021 and 2023. J. Vet. Res. 2024, 68, 215–222. [Google Scholar] [CrossRef] [PubMed]
- Csikós, K.; Varga, J.; Hadházy, Á.; Bándy, P. Babesiosis of dogs: Changes of epidemiology and clinical pattern in Szekszárd between 1992 and 1999. Magy. Állatorvosok Lapja 2001, 123, 259–264. (In Hungarian) [Google Scholar]
- Hornok, S.; Edelhofer, R.; Farkas, R. Seroprevalence of canine babesiosis in Hungary suggesting breed predisposition. Parasitol. Res. 2006, 99, 638–642. [Google Scholar] [CrossRef]
- Bourdoiseau, G. Canine babesiosis in France. Vet. Parasitol. 2006, 138, 118–125. [Google Scholar] [CrossRef]
Disclaimer/Publisher’s Note: The statements, opinions and data contained in all publications are solely those of the individual author(s) and contributor(s) and not of MDPI and/or the editor(s). MDPI and/or the editor(s) disclaim responsibility for any injury to people or property resulting from any ideas, methods, instructions or products referred to in the content. |
© 2024 by the authors. Licensee MDPI, Basel, Switzerland. This article is an open access article distributed under the terms and conditions of the Creative Commons Attribution (CC BY) license (https://creativecommons.org/licenses/by/4.0/).